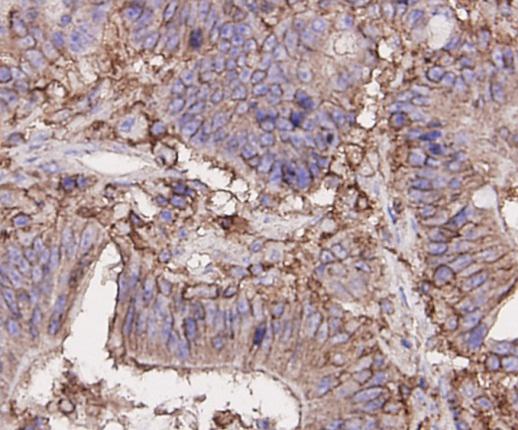
产品细节图片3

相关产品推荐更多 >
万千商家帮你免费找货
0 人在求购买到急需产品
- 详细信息
- 询价记录
- 文献和实验
- 技术资料
- 供应商:
上海信裕生物科技有限公司
- 库存:
50
- 克隆性:
多克隆
- 抗原来源:
Rabbit
- 保质期:
一年
- 抗体英文名:
CD44 Mouse Monoclonal Antibody
- 抗体名:
CD44 Mouse Monoclonal Antibody
- 保存条件:
CD44 Mouse Monoclonal Antibody -20℃保存,Western一抗稀释液-20℃或4℃保存,一年有效。Western一抗稀释液优先推荐4℃保存,长期不使用可以考虑-20℃保存,但冻融可能会导致出现轻微的浑浊和少量不溶物。
WB, Western blot; IP, Immunoprecipitation; IF, Immunofluorescence; IHC, Immunohistochemistry; ICC, Immunocytochemistry; FC, Flow Cytometry; ELISA, Enzyme-linked Immunosorbent Assay; ChIP, Chromatin Immunoprecipitation Assay.
H, Human; M, Mouse; R, Rat; C, Chicken; Cw, Cow; Dg, Dog; Gp, Guinea pig; Hm, Hamster; Hr, Horse; Mk, Monkey; Pg, Pig; Rb, Rabbit; S, Sheep; Z, Zebrafish; All, all species expected.
配套提供了Western一抗稀释液,可以用于Western检测或其它适当用途时的一抗稀释。
建议抗体使用时的稀释比例如下(实际使用时需根据抗原水平的高低作适当调整):
| WB | IP | IF | IHC | ICC | FC | ELISA | ChIP |
| 1:500-1:1000 | - | - | 1:200 | - | 1:100-1:200 | - | - |
抗体详细信息如下:
| About this Antibody | |
| Name | CD44 Mouse Monoclonal Antibody |
| Category | Monoclonal antibody(mAb); Primary antibody |
| Isotype | IgM |
| Purification | ProA affinity purified |
| About the Immunogen | |
| Immunogen | This antibody is produced by immunizing mice with a synthetic peptide (KLH-coupled) corresponding to a region of CD44. |
| Gene ID | 960 |
| SwissProt | P16070 |
| Synonyms | CDW44; CSPG8; ECMR-III; HCELL; IN; LHR; MC56; MDU2; MDU3; MGC10468; MIC4; MUTCH-I; Pgp1 |
| Category | Immunology and Inflammation |
| Background | CD44 is a cell-surface glycoprotein postulated to play a role in a variety of biological processes, including lymphocyte homing and tumor-cell metastasis. It mediates cell-cell and cell-matrix interactions through its affinity for hyaluronic acid (HA), and possibly also through its affinity for other ligands such as osteopontin,collagens, and matrix metalloproteinases (MMPs). Adhesion with HA plays an important role in cell migration, tumor growth and progression. CD44 is highly polymorphic, possesses a number of alternative splice variants and undergoes extensive post-translational modifications. |
包装清单:
| 产品编号 | 产品名称 | 包装 |
| XY-0105 | CD44 Mouse Monoclonal Antibody | 50μl |
| XY-050 | Western一抗稀释液 | 50ml |
| — | 说明书 | 1份 |
保存条件:
CD44 Mouse Monoclonal Antibody -20℃保存,Western一抗稀释液-20℃或4℃保存,一年有效。Western一抗稀释液优先推荐4℃保存,长期不使用可以考虑-20℃保存,但冻融可能会导致出现轻微的浑浊和少量不溶物。
注意事项:
如果本抗体用于Western blot (WB)、免疫荧光(IF)、免疫细胞化学(ICC)等实验,请注意回收使用过的稀释抗体。回收的抗体通常至少可以重复使用5-10次。稀释后的抗体,包括已经使用过的稀释抗体,请4℃保存。
回收后重复使用的抗体,使用方法同新鲜稀释的抗体。如果在重复使用过程中发现抗体出现轻微混浊现象,可以10,000g离心1-3分钟,取上清用于后续检测。如果回收的抗体出现明显的絮状物或长霉长菌等情况,则可以考虑废弃该抗体。
提供的Western一抗稀释液也可以用于免疫荧光(IF)、免疫组化(IHC)、免疫细胞化学(ICC)等适当用途。如果希望获得最佳的检测效果,请考虑使用上述检测专用的一抗稀释液。
本产品仅限于专业人员的科学研究用,不得用于临床诊断或治疗,不得用于食品或药品,不得存放于普通住宅内。
为了您的安全和健康,请穿实验服并戴一次性手套操作。
使用说明:
请根据抗体的实际用途选择相应的使用方法。
1. Western检测:
A. 按照推荐的稀释比例用信裕生物提供的Western一抗稀释液稀释抗体。
B. 把经过封闭的蛋白膜与稀释好的一抗4℃缓慢摇动过夜或室温缓慢摇动2小时,确保稀释的抗体至少能在摇动的瞬间覆盖蛋白膜。
C. 回收稀释的一抗,4℃保存以备下次继续使用。
D. 按照Western的实验步骤进行后续的洗涤、二抗孵育、洗涤和检测等操作。
2. 免疫染色:
可以使用信裕生物生产的免疫染色一抗稀释液(P0103)稀释抗体,使用后注意回收稀释好的一抗,
3. 其它实验操作请自行参考适当的protocol进行。
4. 代表性图片:
![]() |
![]() |
| Fig. 1. Western blot analysis of CD44 on different cell lysates using anti- CD44 antibody at 1/500 dilution. Positive control: Line1: HUVEC Line2: HL-60 Line3: Hela Line4:SKOV3 | Fig. 2. Immunohistochemical analysis of paraffin-embedded human tonsil tissue using anti-CD44 antibody. Counter stained with hematoxylin. |
![]() |
![]() |
| Fig. 3. Immunohistochemical analysis of paraffin-embedded human colon carcinoma tissue using anti-CD44 antibody. Counter stained with hematoxylin. | Fig. 4. Flow cytometric analysis of Hela cells with CD44 antibody at 1/100 dilution (blue) compared with an unlabelled control (cells without incubation with primary antibody; red).Goat anti mouse IgG (FITC) was used as the secondary antibody. |
风险提示:丁香通仅作为第三方平台,为商家信息发布提供平台空间。用户咨询产品时请注意保护个人信息及财产安全,合理判断,谨慎选购商品,商家和用户对交易行为负责。对于医疗器械类产品,请先查证核实企业经营资质和医疗器械产品注册证情况。
- 作者
- 内容
- 询问日期
文献和实验Monoclonal Antibody Production
and screening of the hybridomas: 1. Bleeding Mice (1) Place the mouse in a mouse restrainer. (2) Sterilize the tail with 70% ethanol. (3) With a razor blade,nip off the last 2 mm of the tip of the tail. (4) Using a milking motion,pull blood down and let
指仅对一种抗原决定基的纯粹的抗体。这类抗体不可能通过将抗原 胞的 Hybridoma,在试管内制成了纯粹的单克隆抗体。用某种抗原使动物产生免疫感应,对应于抗原之不同部分可制成各种不同的抗体复合体。然而,因为一个产生抗体的细胞,只能产生一种抗体,所以骨髓肿瘤细胞与产生抗体细胞间的细胞杂种,可形成边产生抗体边增殖的 hybridoma,将每个杂种细胞进行克隆(无性繁殖系)培养,则一个克隆的细胞群只由单种类产生同一抗体的细胞所组成,这样得到的就是单克隆抗体。此抗体在测定
Monoclonal Antibody Production Protocol
complete with MCM instead of PCM (= IMDM - m ), and keep it in the incubator for fused cells. Isolation of spleen cells Sacrifice mouse by cervical dislocation. Immerse mouse in 70% Ethanol. Remove spleen ( on the left side ) and transfer into a small
技术资料暂无技术资料 索取技术资料